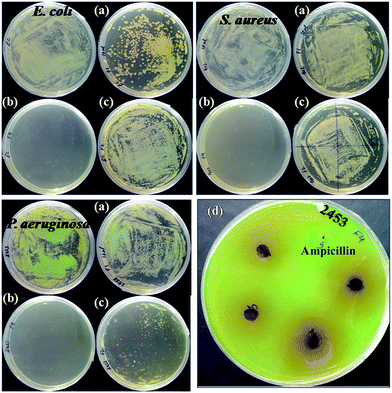

DOI:
10.1039/C5RA20171C
(Paper)
RSC Adv., 2016,
6, 6607-6622
Nanostructured coordination complexes/polymers derived from cardanol: “one-pot, two-step” solventless synthesis and characterization
Received
29th September 2015
, Accepted 17th December 2015
First published on 21st December 2015
Abstract
Growing interests in the development of advanced functional materials from renewable resources due to the depleting petroleum resources, increasing costs, and associated hazards reflect global requirement for increased sustainability. Cardanol [Col] is an agro by-product of the cashew nut industry. It is cost effective, nontoxic, biodegradable and an abundantly available renewable resource. In the present study, we report the development of nanostructured coordination polymer [CP] self-standing transparent films from Col (as an organic linker or bridging-ligand) and Mn(II) ‘d5’ and Co(II) ‘d7’ divalent metal ions (as metal nodes) by a solid-state in situ method. The resulting CP films showed nanoporous morphology, amorphous behaviour, good thermal stability up to 260–300 °C, moderate antibacterial activity against Staphylococcus aureus (MTCC 902), Escherichia coli (ATCC 25922) and Pseudomonas aeruginosa (MTCC 2453) and also good anti-biofilm activity.
Introduction
In the last decade, coordination polymers (CP) or metal–organic frameworks (MOF) or CP gels have attracted great attention in all fields of sciences, mainly because of their important characteristic features, such as porosity, large inner surface area, tunable pore sizes and topologies, and reasonable thermal and mechanical stability, which lead to their versatile architectures.1–5 They have been used in ion exchange,6 gas adsorption and storage in particular of hydrogen and methane,7,8 gas and liquid separation processes,9,10 heterogeneous catalysis,11,12 hosts for metal colloids or nanoparticles or polymerization reactions,13–15 pollutant sequestration,16,17 microelectronics,18,19 luminescence,20,21 non-linear optics,21 magnetism,22 sensor,23–25 drug delivery,26–32 antibacterial agents33,34 and other biomedical applications.4,35 Such materials can be synthesized from the coordination-directed self-assembly of metal ion nodes with organic linkers (or bridging-ligands).36,37
In CP, the choice of the coordinated ligand(s) seems to be as important as the choice of metal(s) for the tailoring of CP for a targeted application, since the geometry and connectivity of an organic linker (or bridging-ligand) determine the structure of the resulting materials. The size, shape and internal surface property of CP for a targeted application can be tuned by adjustments of the linker geometry, length, ratio and functional group.5,38 In general, ligands (organic linkers) and their coordination complexes/polymers are petro-based and involve multi-step synthesis processes using volatile organic solvents, with limited solubility.3,4,38 The synthesis of CP by adopting “Green Chemistry” principles can overcome the aforementioned problems.39 In the present work, we selected cardanol (Col) as an organic linker for the development of renewable-resource-derived nanostructured CP, also keeping in mind the drawbacks mentioned above.
Col(3-pentadecylphenol) is a natural meta-substituted alkyl phenol, a potential natural resource material for biomonomers, obtained from Cashew Nut Shell Liquid (CNSL). It is an agricultural by-product that is abundantly available worldwide, and its production approaches 450
000 tonnes annually.40 Industrial grade Col has around 90% phenol, with C15 hydrocarbon chains with a high degree of unsaturation (aliphatic chain: 5–8% pentadecyl, 48–49% 8Z-pentadecenyl, 16–17% 8Z,11Z-pentadecadienyl and 29–30% 8Z,11Z,14Z-pentadecatrienyl with mainly cis conformation) at the meta position and a small percentage of cardol (5-n-pentadecylresorcinol) and methylcardol (2-methyl-5-n-pentadecylresorcinol).40,41,43 Col has gained interest from scientists and industrialists due to its unique characteristic features such as low viscosity, phenolic hydroxyl groups, high unsaturation (iodine value of 145–151), non-toxicity and biodegradability. In Col, the reactive phenolic hydroxyl group offers synthetic flexibility, while the meta alkyl chain with non-isoprenoic cis double bonds is attributed for its amphiphilic and lipidic character, and the aromatic ring allows for p–p stacking and functionalization. These features collectively make Col a tenable precursor for the development of nanoparticles, various monomers, polymers and functional materials.42–44 These materials have found applications as paints and coatings,45 templating agents,46 foams,47 UV-cured resins,45,48 plasticizers,49,50 reactive diluents,51 epoxy curing agents,41,52 soft materials for drug release,43 antibacterial nanocomposites coatings53,54 and others.
Raj et al. studied the metal ion intake and antibacterial activity of Col-based polymeric Schiff base transition metal complexes using ethylenediamine.55 Jinhuo and Binghuan synthesized and characterized boron–nitrogen coordinating Col-aldehyde polymeric coatings, which showed excellent physico-mechanical and good anticorrosive properties and stability at high temperature.56 Hamad et al. used CNSL as templating agent to prepare a heterogeneous copper(II) Schiff base.46 Ravindranath et al. reported the synthesis and characterization of lipophilic metal derivatives from anacardic acid with an unusually high degree of selectivity and permeability of the metal ions across a liquid membrane.57 Col is thus recognised as a valuable raw material for generating a variety of soft nanomaterials such as nanotubes, nanofibres, gels and surfactants. These nanostructures may then serve as templates for the synthesis of additional nanomaterials, as reported by John et al.43 In another work, the authors synthesized self-standing, metal nanoparticle embedded transparent films from multi-armed Col conjugates through an in situ synthesis.53 Col-furfuraldehyde/maghemite composites were prepared through bulk polymerization to produce magnetic green resins able to absorb petroleum spilled on water, as investigated by Varela and co-workers.58 A literature survey revealed that no work has been reported on the use of Col and its derivatives in the synthesis of nanostructured CP films and their use as antibacterial agents.46,54,55,59
In our research project, we aimed to prepare CP from Col as flexible organic linker and divalent transition metals (of 3d series) as metal nodes. We aimed to investigate the effect of different divalent transition metals (of 3d series) as metal nodes on the properties of the produced CP. To start with, we selected Mn(II) with half-filled d-orbital ‘d5’ and Co(II) with partially filled d-orbital ‘d7’ to develop CP [Col-Mn(II) and Col-Co(II)], with Col as the flexible organic linker and Mn(II) and Co(II) as the metal nodes. Col-Mn(II)C and Col-Co(II)C were characterized by FTIR and UV-visible spectroscopy and magnetic moment. The curing/drying mechanism of the samples was analysed by FTIR-ATR spectral techniques. The morphology of CP was investigated by optical microscopy, SEM-EDX, HR TEM and XRD techniques. TGA/DTA and DSC were used to analyse the thermal behaviour of CP. Preliminary antibacterial efficacy of the samples was tested against Gram positive and Gram negative bacterial isolates [Staphylococcus aureus (MTCC 902) Escherichia coli (ATCC 25922) and Pseudomonas aeruginosa (MTCC 2453)] by the agar disc diffusion method and compared with the standard drug Ampicillin and Col.
Experimental
Materials
Col was procured from Golden Cashew Products (p) LTD, Pondicherry, India [specification: colour: gardeners standard 10; specific gravity at 30 °C: 0.9268; viscosity at 30 °C: 47; iodine value: 235], manganese acetate tetrahydrate [Mn(Ac)2·4H2O, (mol. wt 245.09 g mol−1)], cobalt(II)acetate tetrahydrate (mol. wt 249.08 g mol−1)] and p-toluenesulphonic acid, were purchased from Loba Chemie Pvt. Ltd., Mumbai, and used as received. Müller Hinton agar, nutrient agar, Petri plates, Parafilm were obtained from HiMedia, India, the incubator shaker (Orbitek-LE, India), laminar hood (NSW-201, India) and metal borer were used for the experiment set-up for assessing antimicrobial activity.
Synthesis of Col-M(II) complexes/polymers [Col-Mn(II) and Col-Co(II)]
Col (0.02 mol) and p-toluenesulphonic acid (0.05 wt%) were taken in a four-necked flat bottom flask equipped with a condenser, thermometer and heated for 1 h at 140 ± 5 °C on a magnetic stirrer. The temperature was cooled down and set at 80 ± 5 °C, and finely powdered divalent metal (M) salt [acetates of Mn(II)/Co(II), 0.01 mol, respectively] was slowly added over a period of 15 min with continuous stirring at the same temperature. After the addition of salt, the contents were heated again for 1 h at 95 ± 5 °C on a magnetic stirrer. The reaction was conducted under vacuum for 15 min. The synthesis was confirmed by FTIR recorded at regular intervals and compared with the starting material (Col). The reaction mixtures were observed for clarity and for (any) perceptible changes in the viscosity throughout the course of reaction. CP were obtained as clear, free flowing dark brown liquids as Col-M(II) [Col-Mn(II) and Col-Co(II)] (yield: 89.15 gm).
Preparation of films
The desired amounts of Col-Mn(II) and Col-Co(II), respectively, were poured on Teflon sheets and were then kept undisturbed for drying at room temperature (28–30 °C) for 48–72 h. The free-standing films of Col-Co(II) were obtained at room temperature in 48 h, while Col-Mn(II) films were obtained in 72 h. The thickness of the films was found to be 50–60 μm by an Elcometer (Model 345; Elcometer Instruments, Manchester, UK). It is important to note that pure Col does not form a film at room temperature or at higher temperatures 180–220 °C.
Characterization
The electronic spectra of the samples in xylene were recorded on a UV-vis spectrophotometer (Labtronics LT-2800) at room temperature. Magnetic susceptibility tests were carried out at 25 °C using a Faraday balance. Fourier transform infrared spectroscopy (FTIR) spectra were recorded on an IR Affinity-1 CE spectrometer (Shimadzu corporation analytical and measuring instrument division, Kyoto, Japan) from 4500 to 400 cm−1 with an average 46 scans at 4 cm−1 resolution using a zinc selenide cell. Data acquisition was carried out with IR solution software. Attenuated Total Reflectance (ATR, TENSOR 37 spectrophotometer, Germany) was used to analyze the mode vibration from 4000 to 600 cm−1 with on average 15 scans at 4 cm−1 resolution for sample curing. The analysis was carried out by placing a direct powdered sample onto the Universal diamond ATR top plate and data acquisition was carried out using Opus-Spectroscopic software. 1H-NMR and 13C-NMR spectra were performed on JEOL GSX 300 MHz FX-100 in deuterated chloroform (CDCl3) using tetramethylsilane (TMS) as the internal standard. Optical images of the samples (liquid and powdered) were recorded using a Lietz Optical Microscope Model (Metallux-3, Germany), at 100× magnification. X-ray diffraction (XRD) study was carried out using an X-ray diffractometer (Ultima IV model, Rigaku cooperation, Japan) using Cu Kα radiation ((k 50.15406 nm) and the diffractogram was scanned in the ranges from 10 to 60° at a scan rate of 1° min−1. The surface morphology of the samples was checked with an Environmental Scanning Electron Microscope (model FEI Quanta 200F with Oxford-EDS system IE 250 X Max 80) operating at 20 kV and energy dispersive X-ray spectroscopy (EDX) installed in FE-SEM with gold coating was carried out in the SMITA research lab IIT, Delhi, India, to analyze the elements present. The morphology of the materials (inorganic and organic phase) was examined using High Resolution Transmission Electron Microscopic (HRTEM) with a TECNAI 200 kV TEM operating at 200 kV (Fei, Electron Optics), equipped with digital imaging and a 35 mm photography system, at the All India Institute of Medical Sciences, New Delhi, India. The thermal behaviour of the cured sample was studied with a TGA/DSC1, Mettler Toledo AG, Analytical CH8603, Schwerzenbach, Switzerland) under a nitrogen atmosphere at a heating rate of 10 °C min−1. The thermal behaviour of the uncured materials [rubbery, amorphous or crystalline, melting and phase transformations (Tg)] was analyzed by using a DSC 204F1 system, Netzsch, Germany, under a nitrogen atmosphere. The preliminary antibacterial activity of Col, Col-Mn(II) and Col-Co(II) was determined with respect to ampicillin (as a standard control drug) by the Kirby Bauer method (i.e. disc diffusion assay) against Gram positive [Staphylococcus aureus, MTCC 902] and Gram negative bacteria [Escherichia coli, ATCC 25922 and Pseudomonas aeruginosa, MTCC 2453]. Mueller-Hinton agar (HiMedia India) plates were inoculated by 100 μl of 0.5 McFarland unit grown test organisms to get a uniform load of culture. The test samples were placed in circular wells (6 mm diameter, made with sterilized metal borer) at appropriate distances from the centre. The parafilm-sealed plates were incubated for 12–14 h at 37 °C. After incubation, the zone of growth inhibition (mm) presenting antimicrobial activity of the test compounds was measured. The antimicrobial activity was also determined using the spread plate method. Culture plates containing nutrient agar (HiMedia India) were supplemented with test compound by spreading 10 μl of Col, Col-Mn(II) and Col-Co(II), respectively, on each plate. After incubation at RT for 30 minutes, the plates were inoculated by 100 μl of 0.5 McFarland unit grown test organisms and uniformly spread using a sterilized glass spreader. The parafilm-sealed plates were incubated for 12–14 h at 37 °C and further analysed for bacterial growth.
Results and discussion
Synthesis
Scheme 1 shows the chemical reaction route for the synthesis of Col-M(II). The synthesis was carried out through: (i) acid catalyzed oligomerization42 of Col via addition reaction at the double bond of the long alkyl chain, (ii) followed by metallation by condensation reaction of –OH group of oligomer with metal acetate. These reactions (addition and metallation) forming complexes/polymers were carried out in the same pot without any external agents via a solvent-free solid-state in situ method.60–63 Col serves as the base material, template, reactive diluent and reaction medium (provides functional groups for the chemical transformation) and, due to the presence of the long alkyl chain with non-isoprenoic cis double bonds and reactive phenolic hydroxyl group, it offers synthetic flexibility and functional sites, respectively.43 The overall strategy is highly desirable since: (i) it suggests the novel use of Col, an agro by-product and a renewable feedstock as a starting/raw material to produce CP, (ii) the reaction is accomplished in a shorter time period (2–3 hours), (iii) it uses a simple chemical approach and methodology, i.e. a one-pot two-step synthesis, (iv) it obviates the need for the use of solvents or diluents, or external agents such as cross-linkers, film formers, capping agents, and (v) it employs safer chemistry and follows the principles of Green Chemistry (principles 1, 2, 3, 4, 5, 6, 7, 8, and 12).39 This is an excellent approach to develop self-standing, transparent, scratch resistant, cross-linked polymer films via coordination and autoxidation induced in situ film formation, thus eliminating complex multi-step polymerization processes.
 |
| Scheme 1 Synthesis of CP and their free-standing films, where M = Mn(II) and Co(II). | |
Electronic spectral and magnetic susceptibility analysis
Fig. 1 shows the electronic absorption spectra (UV-vis) of Col, Col-Mn(II) and Col-Co(II). The absorption spectrum of Col (Fig. 1a) shows a band at 277.54 nm (strong and broad). This energy band is also observed in the absorption spectra of Col-Mn(II) and Col-Co(II) (Fig. 1b and c) at 284.52 nm and 296.72 nm, respectively, along with some new bands assigned to π → π* or n → π* transitions of the aromatic phenyl ring. The bathochromic shift (red shift) in the Col-Mn(II) and Col-Co(II) spectra in comparison to Col correlates to the formation of Mn–O and Co–O bonds, respectively, and the complexation of Mn(II) and Co(II) ions with donor groups of ligand.64 The additional energy bands in the spectra of Col-Mn(II) (Fig. 1b) observed at 333 nm, 400 nm and 560 nm are associated with the 4Eg(D) ← 6A1g, 4Eg(G) ← 6A1g and 4T1g(G) ← 6A1g transitions, respectively. In the Col-Co(II) absorption spectra, there is only one additional weak energy band observed at 900–1050 nm, along with a shoulder at 540 nm assigned to 4T2g(F) ← 4T1g(F) and spin-forbidden transitions, respectively.
 |
| Fig. 1 UV-Vis spectra of (a) Col, (b) Col-Mn(II) and (c) Col-Co(II). | |
The magnetic moment values of Col-Mn(II) and Col-Co(II) were calculated to determine the type of coordination around the metal ion. Values of 5.66 BM for Col-Mn(II) and 5.44 BM for Col-Co(II)65,66 were found by determining the magnetic susceptibility of the same. These values correlate to the presence of five unpaired electrons in Col-Mn(II) and three unpaired electrons in Col-Co(II).65,67
Electronic spectral and magnetic moment analyses of Col-Mn(II) and Col-Co(II) reveal high-spin d5 and d7 systems, respectively, with an octahedral geometry around the metal ions in both cases. In the case of Col-Co(II), we found a high magnetic moment. The literature also shows the high magnetic moment value of Co(II) complexes/polymers with an octahedral geometry. It was observed in octahedral Co(II) complexes/polymers that the arrangements have an orbital contribution (t2g)1(eg)0(t2g)2(eg)0(t2g)4(eg)2(t2g)5(eg)2]. Due to this orbital contribution [(t2g)5(eg)2] of Co(II), the complexes/polymers show a high value of magnetic moment.68
FTIR spectral analysis (Fig. 2)
Fig. 2a shows the FTIR spectral bands of Col. The characteristic bands are observed at 3354.21 cm−1 (–OH intermolecular hydrogen bonded), 3076.46 cm−1 (C
C–H aromatic, Ar), 3008.98 cm−1 (C
C–H), 2926.01 cm−1 and 2854.66 cm−1 (CH3, –CH2 sym and asymm), 1614.42 cm−1 and 1589.34 cm−1 (Ar and aliphatic C
C str.), 1456.26 cm−1 (C–H bending), 1361.74 cm−1 (OH bending in plane), 1265.30 cm−1 and 1156.36 cm−1 (phenol C–O str.), 1072.42 cm−1 (C–OH), 1049.28 cm−1 (Ar
C–H bending, in plane and out of plane, very small peak), 999.13 (Ar C
C), 912.33 cm−1 and 873.75 cm−1 (C–H bending of mono substituted alkene), 779.24 cm−1 and 694.37 cm−1 (Ar
C–H deformation of three adjacent hydrogen atoms), respectively.69,70
 |
| Fig. 2 FTIR spectra of (a) Col, (b) Col-Co(II) and (c) Col-Mn(II). | |
Fig. 2b shows the FTIR spectra of Col-Mn(II) and Fig. 2c shows the FTIR spectral analysis of Col-Co(II). In the spectra of Col and Col-M(II), the main changes are observed in the vibrational modes of phenolic –OH, C
C str. and C–OH, along with presence of an additional mode at 611 cm−1 (Mn–O) and 615 cm−1 (Co–O).71
The first step in the formation of CP is the oligomerisation of Col, which is supported by the typical changes in the FTIR of Col-Mn(II) and Col-Co(II), namely
(i) Phenolic –OH in Col-Mn(II) and Col-Co(II) are observed at 3348.42 cm−1 and 3319.49 cm−1, respectively, as suppressed bands relative to –OH of Col, appearing at 3354.21 cm−1.
(ii) The absorption band at 1614.42 cm−1 for unsaturation appears as a suppressed band in comparison to Col, supporting the oligomerisation of Col.42,72
The second step in the formation of CP is metallation of the in situ synthesised oligomer of Col. This is correlated to the shifting of the C
C–H Ar absorption bands at 3070.49 cm−1 and 3070.68 cm−1, and C
C str. at 1595.13 cm−1 and 1591.13 cm−1, respectively, in Col-Mn(II) and Col-Co(II), compared to Col (3076.46 cm−1 and 1589.3 cm−1). The vibrational mode of C–OH for Col-Mn(II) is suppressed and observed at 1078.21 cm−1, whereas it disappears in the Col-Co(II) spectrum. The spectra reveal that the vibrational modes at 1265.30 cm−1 (phenol C–O str.) and 1456.26 cm−1 (C–H bending) are suppressed and broad in Col-M(II), due to reaction of phenolic –OH with metal acetate through the formation of a –O–M–O– bond along with coordination with donor groups such as O and C
C.
NMR spectral analysis (Fig. 3 and 4)
1H-NMR (Fig. 3) and 13C-NMR (Fig. 4) spectral analysis of Col, Col-Mn(II) and Col-Co(II) showed the following characteristic peaks:
 |
| Fig. 3 1H-NMR spectra of Col, Col-Mn(II) and Col-Co(II). | |
 |
| Fig. 4 13C-NMR spectra of Col, Col-Mn(II) and Col-Co(II). | |
Col. 1H-NMR (300 MHz, CDCl3): δ 0.76–0.90 (CH3/CH2, n), 1.134–1.25 (chain –CH2–, h), 1.4 (CH2–CH2–Ar, g), 1.84–1.88 (CH2–CH
CH, i), 2.34–2.39 (CH2–Ar, f), 2.62–2.65 (–CH
CH–CH2–CH
CH, k), 5.23 (CH
CH, j), 5.64–5.66 (CH
CH2, l), 4.8–4.85 (CH
CH2, m), 6.45–7.07 (Ar–H, b, c, d, e), 4.9 (non hydrogen bonded Ar–O–H, a) and 4.3 (broad, hydrogen bonded Ar–O–H, a′) ppm.13C-NMR (300 MHz, CDCl3): δ 13.80–14.11 (CH3, n), 22.68–29.77 (chain –CH2–, h), 31.28–35.85 (–CH
CH–CH2–, m, p, j), 112.56–129.86 (CH
CH, CH
CH2 and CH
CH2, k, l, n, o, q, r), 130.16–138.86 (ArC, b, c, d, f), 155.56 (ArC–OH, a) and 144.92 (ArC–R, e) ppm.
Col-Mn(II). 1H-NMR (300 MHz, CDCl3): δ 0.89, 0.72 (CH3/CH2,n), 1.13 (chain –CH2–, h), 1.4 (CH2–CH2–Ar, g), 1.85 (CH2–CH
CH, i), 2.36 (CH2–Ar, f), 2.62 (–CH
CH–CH2–CH
CH, k), 5.19 (CH
CH, j), 5.64 (CH
CH2, l), 4.8–4.84 (CH
CH2,m), 6.56–6.95 (Ar–H,b, c, d, e) and 4.9 (non hydrogen bonded Ar–O–H, a) ppm.13C-NMR (300 MHz, CDCl3): δ 13.82–14.14 (CH3,n), 22.69–29.78 (chain –CH2–, h), 31.30–35.88 (–CH
CH–CH2–, m, p, j), 112.76–129.88 (CH
CH, CH
CH2 and CH
CH2,k, l, n, o, q, r), 130.17–136.86 (ArC, b, c, d, f), 155.85 (ArC–OH, a) and 144.92 (ArC–R, e) ppm.
Col-Co(II). 1H-NMR (300 MHz, CDCl3): δ 1, 0.9 (CH3/CH2, n), 1.32 (chain –CH2–, h), 1.6 (CH2–CH2–Ar, g), 2.04 (CH2–CH
CH, i), 2.55 (CH2–Ar, f), 2.81 (–CH
CH–CH2–CH
CH, k), 5.37 (CH
CH, j), 5.83 (CH
CH2, l), 5.0–5.09 (CH
CH2,m), 6.56–6.95 (Ar–H, b, c, d, e) and 5.17 (non hydrogen bonded Ar–O–H, a) ppm.13C-NMR (300 MHz, CDCl3): δ 14.09 (CH3, n), 22.65–29.70 (chain –CH2–, h), 31.26–35.83 (–CH
CH–CH2–, m, p, j), 112.52–129.87 (CH
CH, CH
CH2 and CH
CH2, k, l, n, o, q, r), 129.96–136.86 (ArC, b, c, d, f), 155.80 (ArC–OH, a) and 144.92 (ArC–R, e) ppm.
1H-NMR and 13C-NMR revealed that the double bond and ArC–OH peaks are suppressed in the Col-Mn(II) and Col-Co(II) spectra as compared to Col, which can be correlated to the oligomerization occurring at the double bonds of the chains, followed by metallation at ArC–OH, as also observed in FTIR.51 The Col-Mn(II) and Col-Co(II) spectra reveal suppression of active methylene peak in 1H-NMR and 13C-NMR spectra. The disappearance of hydrogen bonded –OH present in 1H-NMR spectrum of Col is also evident.
More (than expected) signals for carbons are also observed in the spectra due to the different degrees of saturation.51
It was observed that Co(II)-based film cured faster than Mn(II)-based materials. The curing was initially confirmed by refluxing the cured specimen in xylene for 12 h to dissolve and extract any soluble component present. There were no soluble fractions detected in the solvent, which suggested that Col-Mn(II) and Col-Co(II) were fully cross-linked, which made them insoluble. The curing of Col-Mn(II) and Col-Co(II) occurs by cross-linking of polymeric chains through electrostatic interactions of Mn(II) and Co(II) with donor groups such as oxygen and by double bonds, along with fast autoxidation.71,53 The autoxidation of long unsaturated alkyl chain with atmospheric oxygen is faster due to the presence of divalent metal. The proposed curing mechanism was confirmed by taking the ATR-FTIR of cured Col-Mn(II) and Col-Co(II) samples (Fig. 5a and b) and comparing these with the uncured FTIR spectra of the same (Fig. 2). The spectra reveal a broadening and shifting of phenolic –OH and C–O and the disappearance of the vibrational mode at 3008 cm−1 for C
C–H.53 Closer examination of the spectra of both Col-Mn(II) and Col-Co(II) implies the presence of an additional mode at 1700–1709 cm−1 for ketone > C
O str. This can be correlated to oxidation of allylic double bond in presence of Mn2+ and Co2+, which results in formation of ketone [CH
CH–C(
O)–CH2–].69
 |
| Fig. 5 ATR of cured samples at room temperature (a) Col-Mn(II) and (b) Col-Co(II). | |
Generally, the autoxidation of long unsaturated alkyl chains is a very slow process (takes more than 10 days). It is reported that metal ions increase the rate of autoxidation, which leads to curing at room temperature in shorter time than observed in the present case. It is reported that metal ions (Co2+, Mn2+, etc.) are used to speed up the autoxidation and allylic double bond oxidation process.71 In the present case, Mn(II) and Co(II) present in the backbone readily and inherently participate in the autoxidation and allylic double bond oxidation reaction, speeding up the same, leading to drying/curing at room temperature in a shorter time period. The fast curing of Co(II)-based materials is due to the presence of partially filled ‘d’ orbital.
Morphology
XRD (Fig. 6). XRD (Fig. 6) micrographs of Col-Mn(II) and (b) Col-Co(II) show broad bands at 2 theta = 20° and 19°, respectively, related to the amorphous behaviour of both CPs. This behaviour of CP can be due to the presence of long alkyl chains in the backbone that hinder packing of the polymer chains and decrease the intermolecular forces, and subsequently cause a decrease in crystallinity.69 The XRD behaviour can be further supported by the presence of a broad endotherm in the DSC thermogram (Section 4.7, Fig. 13).
 |
| Fig. 6 XRD micrograph of (a) Col-Mn(II) and (b) Col-Co(II). | |
Optical microscopy (Fig. 7). Optical micrographs of Col-Mn(II) and Col-Co(II) (Fig. 7a and b) show the presence of spherical particles embedded in the matrix in a well arranged pattern.
 |
| Fig. 7 Optical micrograph of (a) Col-Mn(II) and (b) Col-Co(II) at magnification 100×. | |
FE-SEM (Fig. 8 and 9). The surface morphology of powdered films was investigated by viewing FE-SEM images of Col-Mn(II) and Col-Co(II) at different magnifications, as shown in Fig. 8 and 9. The images in both cases imply that Col-Mn(II) and Col-Co(II) are made up of spherical particles [as observed in HRTEM (Fig. 10 and 11)] with smooth surface, which agglomerate to form a nanoporous (pore size 58 nm to 260 nm) and layered morphology.
 |
| Fig. 8 SEM images at different magnifications (a–c) and (d) EDX surface scanning of Col-Mn(II). | |
 |
| Fig. 9 SEM images at different magnifications (a–c) and (d) EDX surface scanning of Col-Mn(II). | |
 |
| Fig. 10 HRTEM micrographs of Col-Mn(II) at different magnifications. | |
 |
| Fig. 11 HRTEM micrographs of Col-Mn(II) at different magnifications. | |
SEM-EDX (Fig. 8d and 9d). EDX surface scanning of Col-Mn(II) and Col-Co(II) of the powdered films was determined in order to know the elemental composition in the same (Fig. 8d and 9d). EDX analysis of Col-M(II) represents the atomic percentage (%) of Mn (4.86) and Co (1.91), which corroborates the presence of Mn in Col-Mn(II) and Co in Col-Co(II) along with carbon and oxygen.
HRTEM (Fig. 10 and 11). HRTEM of CP show the presence of nano- to microspheres (dark contrast) with well-defined boundaries, forming a closely linked network in the case of Col-Mn(II) (Fig. 10) due to high electrostatic interactions. In HRTEM micrograph of Col-Co(II) (Fig. 11), there exist distinct transparent (hollow) nano- to microspheres with well-defined boundaries touching each other, showing clear contact points and air pockets. These micro- and nanospheres are composed of polymerized metal–ligand networks, which may be made possible by the coordination-chemistry-induced assembly of metal ions and cardanol building blocks.3
By taking TGA-DTA thermograms of Col-Mn(II) and Col-Co(II) films, respectively (Fig. 12a and b), we show that there are three stages observed in the thermograms due to different phenomenon occurring in each stage: 1st stage at 95–105 °C, 2nd at 175–325 °C and 3rd stage at 325–520 °C. The first stage of weight loss may be correlated to the evaporation of entrapped moisture or coordinated water molecules. The second weight loss may be correlated to cross-linking due to condensation and coordination reaction between functional groups such as –OH, –CH2–CH
CH–, Ar–CH
CH–; note, the same is observed as an endotherm in the DSC thermogram of Col-M(II) (Fig. 12 and 13). The third stage (main stage) is correlated to the decross-linking followed by breaking of the hydrocarbons (aliphatic and aromatic), as also observed as a prominent endotherm in the DSC thermogram of Col-M(II) (Fig. 12 and 13), followed by the degradation of metallic bonds and subsequently volatilization of the decomposition products.
 |
| Fig. 12 TGA-DTA of (a) Col-Mn(II) and (b) Col-Co(II). | |
 |
| Fig. 13 DSC thermogram of Col (a) and uncured Col-M(II) (b), where M = Mn(II) and Co(II). | |
In the DSC thermogram (Fig. 13), Tg for uncured Col-Mn(II) and Col-Co(II) are observed at 109.42 and 109.02 °C, while in Col, Tg was observed at 84.04 °C. The higher Tg in Col-M(II) than in Col correlates to the metal coordination. DSC thermogram of the cured Col-Co(II) (Fig. 14) shows the same Tg as observed in the DSC of the uncured sample and also reveals that there is no change between 175–325 °C, which correlates to the temperature range in which cross-linking occurred during the DSC scan.54 It is important to note that the 2nd endotherm in DSC occurring between 175 to 325 °C observed in Col-Mn(II) and Col-Co(II) and Col is correlated to Col (ligand) chain in Col-M(II); the higher thermal stability of films is also correlated to Col moieties.54
 |
| Fig. 14 DSC thermogram of cured samples of (a) Col-Mn(II), and (b) Col-Co(II). | |
|
| Fig. 15 Plate spread method of Col (a), Col-Co(II) (b), Col-Mn(II) (c) against E. coli, S. aureus and P. aeruginosa, and (d) film inhibition by Col-Co(II) against P. aeruginosa at different concentrations 1–4 using the standard drug ampicillin (code 5). Bacterial colonies and film inhibition were measured after 12–14 h at 37 °C. | |
Antibacterial behaviour (Fig. 15)
The test samples Col-Mn(II) and Col-Co(II) had antimicrobial activity on bacterial growth, which was observed in the form of a zone of growth inhibition.73,74 Col-M(II) at a concentration of 250 μg ml−1 was able to inhibit the growth of S. aureus and E. coli with a zone of inhibition diameter of 8 mm, but had no effect on P. aerugenosa. Col-Co(II) showed a zone of inhibition diameter of 11 mm with both S. aureus and E. coli but with no effect on the growth of P. aerugenosa. However, Col-Co(II) was observed to have an anti-biofilm effect on P. aerugenosa. P. aeruginosa is a biofilm (BF) forming bacteria and has been found to be involved in a wide variety of microbial infections in the body (Table 1). BF is an assemblage of microorganisms in which cells attach to each other on a living or non- living surface and these cells are frequently embedded within a self produced matrix of extracellular polymeric substance (EPS) composed of nucleic acids, amino acids, carbohydrates and various ions.75 There are many factors and genes that affect BF formation. PSL operon (consisting of nearly 15 genes) is generally believed to be responsible for the initiation and sustenance of the biofilm. The cell-to-cell and cell-to-surface interactions required for cell communication and the sequestering of EPS are also governed by these genes. The EPS matrix imparts a strong defence mechanism for the survival of microbes in harsh conditions and to antimicrobial agents present in the vicinity.
Table 1 Antibacterial activity of test samples, where ZOI: zone of inhibition and FI: film inhibition
S. No. |
Antibacterial agents |
S. aureus (MTCC 902) ZOI (mm) |
E. coli (ATCC 25922) ZOI (mm) |
P. aeruginosa (MTCC 2453) ZOI (mm) FI (mm) |
1 |
Col |
7 |
10 |
0 |
0 |
2 |
Col-Mn(II) |
8 |
8 |
0 |
0 |
3 |
Col-Co(II) |
11 |
11 |
0 |
16 |
4 |
Ampicillin |
24 |
0 |
0 |
0 |
The antimicrobial results of the spread plate method were in concordance with the disc diffusion method, supporting the antimicrobial activity of the test compounds. The sensitivity of the bacterial strains S. aureus (MTCC 902), E. coli (ATCC 25922) and P. aeruginosa (MTCC 2453) were more for Col-Mn(II) than Col alone. Interestingly, E. coli ATCC 25922 was more sensitive to Col than Col-Mn(II). Moreover, in the case of Col-Co(II), the complete absence of bacterial growth was observed for all three bacterial isolates. The antibacterial activity of Col-Co(II) is higher in comparison to that of the reported Col Schiff base Co(II) complexes.55,76
The antimicrobial property of the synthesized nanostructured coordination complexes/polymer would facilitate the inhibition of bacterial growth on medical devices. Although the antimicrobial effect of these polymers was not comparable to the antibiotic ampicillin, Col-Co(II) was observed to have comparably more antibacterial effect than Col-Mn(II). This increased activity could be attributed to the metal ion Co2+, which has a greater bactericidal effect in comparison to Mn2+. The anti-biofilm activity of Col-Co(II) needs to be further evaluated to prevent the survival of microbes in EPS matrix.
Conclusion
In the present work, we presented an innovative, widely applicable, straightforward, rapid, inexpensive and environmentally friendly method to prepare Col-based nanostructured CP [Col-Mn(II) and Col-Co(II)] with antibacterial activity. In CP system, an immense number of metal ions [divalent Co(II) and Mn(II) ions] and Col (as an organic flexible linker) were pieced together in octahedral geometry, and formed micro- to nanospheres that agglomerated to form amorphous, nanoporous, layered morphology with desirable anti-biofilm activity and high thermal stability. As an exciting achievement, this work demonstrated an eco-design of a bio-based CP in which an immense number of metal centres and (Col) organic blocks can be anchored together and specifically tailored to achieve eco-friendly materials with desirable characteristics for application in dyes and gases adsorption, as drug carriers, catalysts, biomedical devices, anticancer, antimicrobial agents, catalysis, chemical sensors, targeted drug release and others. The manuscript covered our studies on Col-CP from Mn(II) and Co(II); Col-CP from other metals in 3-d transition metal series will be investigated and reported in future publications and, based upon the properties conferred to Col-CP by different transition metals, a comparative study will also be conducted.
Acknowledgements
Dr Fahmina Zafar is thankful to the University Grants Commission, India for Dr D. S. Kothari Post Doctoral Fellowship, Ref. #F.4/2006(BSR)/13-986/2013(BSR) with Prof. Nahid Nishat. Dr F. Zafar is also thankful to the Head, Dept of Chemistry, Jamia Millia Islamia, New Delhi, India, for providing the facilities to carry out the research work. Author Mudsser Azam acknowledge CSIR for financial support as SRF (Ref# 0.09/466(0136)/2011-EMR-I). Authors also thanks to All India Institute of Medical Sciences for HR TEM micrographs and Center Instrumentation facilities (CIF), Centre for Interdisciplinary Research in Basic Sciences, Jamia Millia Islamia for ATR.
References
- D. Bradshaw, S. El-Hankari and L. Lupica-Spagnolo, Chem. Soc. Rev., 2014, 43, 5431 RSC.
- A. Stoddart, Nat. Mater., 2015, 14, 362 CrossRef CAS.
- M. Oh and C. A. Mirkin, Nature, 2005, 438, 651 CrossRef CAS PubMed.
- S. Keskin and S. Kızılel, Ind. Eng. Chem. Res., 2011, 50, 1799 CrossRef CAS.
- Z.-J. Lin, J. Lü, M. Hong and R. Cao, Chem. Soc. Rev., 2014, 43, 5867 RSC.
- Q. Yao, J. Sun, K. Li, J. Su, M. V. Peskov and X. Zou, Dalton Trans., 2012, 41, 3953 RSC.
- Y. Li and R. T. Yang, Langmuir, 2007, 23, 12937 CrossRef CAS PubMed.
- H. Furukawa and O. M. Yaghi, J. Am. Chem. Soc., 2009, 131, 8875 CrossRef CAS PubMed.
- J.-R. Li, J. Sculley and H.-C. Zhou, Chem. Rev., 2011, 112, 869 CrossRef PubMed.
- A. U. Czaja, N. Trukhan and U. Müller, Chem. Soc. Rev., 2009, 38, 1284 RSC.
- T. Zhang and W. Lin, Chem. Soc. Rev., 2014, 43, 5982 RSC.
- J. Liu, L. Chen, H. Cui, J. Zhang, L. Zhang and C.-Y. Su, Chem. Soc. Rev., 2014, 43, 6011 RSC.
- C. Janiak and J. K. Vieth, New J. Chem., 2010, 34, 2366 RSC.
- T. Uemura, N. Yanai and S. Kitagawa, Chem. Soc. Rev., 2009, 38, 1228 RSC.
- R. K. Bhakta, J. L. Herberg, B. Jacobs, A. Highley, R. Behrens Jr, N. W. Ockwig, J. A. Greathouse and M. D. Allendorf, J. Am. Chem. Soc., 2009, 131, 13198 CrossRef CAS PubMed.
- R. Ricco, L. Malfatti, M. Takahashi, A. J. Hill and P. Falcaro, J. Mater. Chem. A, 2013, 1, 13033 CAS.
- C. M. Doherty, E. Knystautas, D. Buso, L. Villanova, K. Konstas, A. J. Hill, M. Takahashi and P. Falcaro, J. Mater. Chem., 2012, 22, 11470 RSC.
- S. Eslava, L. Zhang, S. Esconjauregui, J. Yang, K. Vanstreels, M. R. Baklanov and E. Saiz, Chem. Mater., 2012, 25, 27 CrossRef.
- M. Usman, S. Mendiratta and K. L. Lu, ChemElectroChem, 2015, 2, 786 CrossRef CAS.
- J. Rocha, L. D. Carlos, F. A. A. Paz and D. Ananias, Chem. Soc. Rev., 2011, 40, 926 RSC.
- J.-P. Zou, Q. Peng, Z. Wen, G.-S. Zeng, Q.-J. Xing and G.-C. Guo, Cryst. Growth Des., 2010, 10, 2613 CAS.
- R.-Q. Zhong, R.-Q. Zou, M. Du, T. Yamada, G. Maruta, S. Takeda, J. Li and Q. Xu, CrystEngComm, 2010, 12, 677 RSC.
- S. Achmann, G. Hagen, J. Kita, I. M. Malkowsky, C. Kiener and R. Moos, Sensors, 2009, 9, 1574 CrossRef CAS PubMed.
- Z. Hu, B. J. Deibert and J. Li, Chem. Soc. Rev., 2014, 43, 5815 RSC.
- Y. Xiao, Y. Cui, Q. Zheng, S. Xiang, G. Qian and B. Chen, Chem. Commun., 2010, 46, 5503 RSC.
- J. Della Rocca, D. Liu and W. Lin, Acc. Chem. Res., 2011, 44, 957 CrossRef CAS PubMed.
- P. Horcajada, T. Chalati, C. Serre, B. Gillet, C. Sebrie, T. Baati, J. F. Eubank, D. Heurtaux, P. Clayette and C. Kreuz, Nat. Mater., 2010, 9, 172 CrossRef CAS PubMed.
- P. Horcajada, C. Serre, M. Vallet-Regí, M. Sebban, F. Taulelle and G. Férey, Angew. Chem., 2006, 118, 6120 CrossRef.
- I. Imaz, M. Rubio-Martínez, L. García-Fernández, F. García, D. Ruiz-Molina, J. Hernando, V. Puntes and D. Maspoch, Chem. Commun., 2010, 46, 4737 RSC.
- H.-Y. Lian, M. Hu, C.-H. Liu, Y. Yamauchi and K. C.-W. Wu, Chem. Commun., 2012, 48, 5151 RSC.
- W. J. Rieter, K. M. Pott, K. M. Taylor and W. Lin, J. Am. Chem. Soc., 2008, 130, 11584 CrossRef CAS PubMed.
- K. M. Taylor-Pashow, J. D. Rocca, Z. Xie, S. Tran and W. Lin, J. Am. Chem. Soc., 2009, 131, 14261 CrossRef CAS PubMed.
- X. Lu, J. Ye, D. Zhang, R. Xie, R. F. Bogale, Y. Sun, L. Zhao, Q. Zhao and G. Ning, J. Inorg. Biochem., 2014, 138, 114 CrossRef CAS PubMed.
- C. Tamames-Tabar, E. Imbuluzqueta, N. Guillou, C. Serre, S. R. Miller, E. Elkaïm, P. Horcajada and M. J. Blanco-Prieto, CrystEngComm, 2015, 17, 456 RSC.
- L.-L. Tan, H. Li, Y.-C. Qiu, D.-X. Chen, X. Wang, R.-Y. Pan, Y. Wang, S. X.-A. Zhang, B. Wang and Y.-W. Yang, Chem. Sci., 2015, 6, 1640 RSC.
- O. M. Yaghi, M. O'Keeffe, N. W. Ockwig, H. K. Chae, M. Eddaoudi and J. Kim, Nature, 2003, 423, 705 CrossRef CAS PubMed.
- S. Kitagawa, R. Kitaura and S. I. Noro, Angew. Chem., Int. Ed., 2004, 43, 2334 CrossRef CAS PubMed.
- W. Lu, Z. Wei, Z.-Y. Gu, T.-F. Liu, J. Park, J. Park, J. Tian, M. Zhang, Q. Zhang and T. Gentle III, Chem. Soc. Rev., 2014, 43, 5561 RSC.
- P. Anastas and N. Eghbali, Chem. Soc. Rev., 2010, 39, 301 RSC.
- S. Baader, P. Podsiadly, D. Cole-Hamilton and L. Goossen, Green Chem., 2014, 16, 4885 RSC.
- R. M. Auvergne, S. Caillol, G. David, B. Boutevin and J.-P. Pascault, Chem. Rev., 2013, 114, 1082 CrossRef PubMed.
- C. Voirin, S. Caillol, N. V. Sadavarte, B. V. Tawade, B. Boutevin and P. P. Wadgaonkar, Polym. Chem., 2014, 5, 3142 RSC.
- V. S. Balachandran, S. R. Jadhav, P. K. Vemula and G. John, Chem. Soc. Rev., 2013, 42, 427 RSC.
- J. Chen, Z. Liu, J. Jiang, X. Nie, Y. Zhou and R. E. Murray, RSC Adv., 2015, 5, 56171 RSC.
- R. Liu, X. Zhang, J. Zhu, X. Liu, Z. Wang and J. Yan, ACS Sustainable Chem. Eng., 2015, 3, 1313 CrossRef CAS.
- F. Hamad, E. Mubofu and Y. Makame, Catal. Sci. Technol., 2011, 1, 444 CAS.
- K. I. Suresh, ACS Sustainable Chem. Eng., 2012, 1, 232 CrossRef.
- R. Liu, G. Zhu, Z. Li, X. Liu, Z. Chen and S. Ariyasivam, Green Chem., 2015, 17, 3319 RSC.
- S. Mohapatra and G. B. Nando, RSC Adv., 2014, 4, 15406 RSC.
- P. Yang, J. Yan, H. Sun, H. Fan, Y. Chen, F. Wang and B. Shi, RSC Adv., 2015, 5, 16980 RSC.
- J. Chen, X. Nie, Z. Liu, Z. Mi and Y. Zhou, ACS Sustainable Chem. Eng., 2015, 3, 1164 CrossRef CAS.
- Y. Liu, J. Wang and S. Xu, J. Polym. Sci., Part A: Polym. Chem., 2014, 52, 472 CrossRef CAS.
- K. Jyothish, P. K. Vemula, S. R. Jadhav, L. C. Francesconi and G. John, Chem. Commun., 2009, 36, 5368 RSC.
- Y.-S. Choi, K.-H. Kim, D.-G. Kim, H. J. Kim, S.-H. Cha and J.-C. Lee, RSC Adv., 2014, 4, 41195 RSC.
- C. I. S. Raj, M. Christudhas and G. A. G. Raj, J. Chem. Pharm. Res., 2011, 3, 127 CAS.
- L. Jinhuo and H. U. Binghuan, Chin. J. Polym. Sci., 1998, 16, 219 Search PubMed.
- K. Nagabhushana, S. Shobha and B. Ravindranath, J. Nat. Prod., 1995, 58, 807 CrossRef CAS.
- A. Varela, G. Oliveira, F. Souza, C. Rodrigues and M. Costa, Polym. Eng. Sci., 2013, 53, 44 CAS.
- S. Gopalakrishnan, N. Nevaditha and C. Mythili, J. Chem. Pharm. Res., 2011, 3, 490 CAS.
- S. Ahmad, S. Ashraf and F. Zafar, J. Appl. Polym. Sci., 2007, 104, 1143 CrossRef CAS.
- F. Zafar, M. H. Mir, M. Kashif, E. Sharmin and S. Ahmad, J. Inorg. Organomet. Polym. Mater., 2011, 21, 61 CrossRef CAS.
- F. Zafar, H. Zafar, E. Sharmin, S. Ashraf and S. Ahmad, J. Inorg. Organomet. Polym. Mater., 2011, 21, 646 CrossRef CAS.
- E. Sharmin, O. ur Rahman, F. Zafar, D. Akram, M. Alam and S. Ahmad, RSC Adv., 2015, 5, 47928 RSC.
- Y. Li and T. Michinobu, J. Mater. Chem., 2012, 22, 9513 RSC.
- G. G. Mohamed and Z. A. El-Wahab, J. Therm. Anal. Calorim., 2003, 73, 347 CrossRef CAS.
- N. Nishat, S. Dhyani and S. Hasnain, Polym. Bull., 2010, 64, 523 CrossRef CAS.
- K. C. de Berg and K. J. Chapman, J. Chem. Educ., 2001, 78, 670 CrossRef CAS.
- A. M. Virparia, PhD thesis, Saurashtra University, 2013.
- W. Bai, X. Xiao, Q. Chen, Y. Xu, S. Zheng and J. Lin, Prog. Org. Coat., 2012, 75, 184 CrossRef CAS.
- B. Lochab, S. Shukla and I. K. Varma, RSC Adv., 2014, 4, 21712 RSC.
- N. Nishat, M. Zulfequar, Asma and S. Hasnain, J. Coord. Chem., 2010, 63, 1273 CrossRef CAS.
- S. Manjula, V. Kumar and C. Pillai, J. Appl. Polym. Sci., 1992, 45, 309 CrossRef CAS.
- A. J. Driscoll, N. Bhat, R. A. Karron, K. L. O'Brien and D. R. Murdoch, Clin. Infect. Dis., 2012, 54, S159 CrossRef PubMed.
- C. Valgas, S. M. D. Souza, E. F. Smânia and A. Smânia Jr, Braz. J. Microbiol., 2007, 38, 369 CrossRef.
- T. K. Wood, Environ. Microbiol., 2009, 11, 1 CrossRef CAS PubMed.
- C. I. S. Raj, C. M. Sofia and M. A. Princela, Asian J. Res. Chem., 2014, 7, 711 Search PubMed.
|
This journal is © The Royal Society of Chemistry 2016 |
Click here to see how this site uses Cookies. View our privacy policy here.